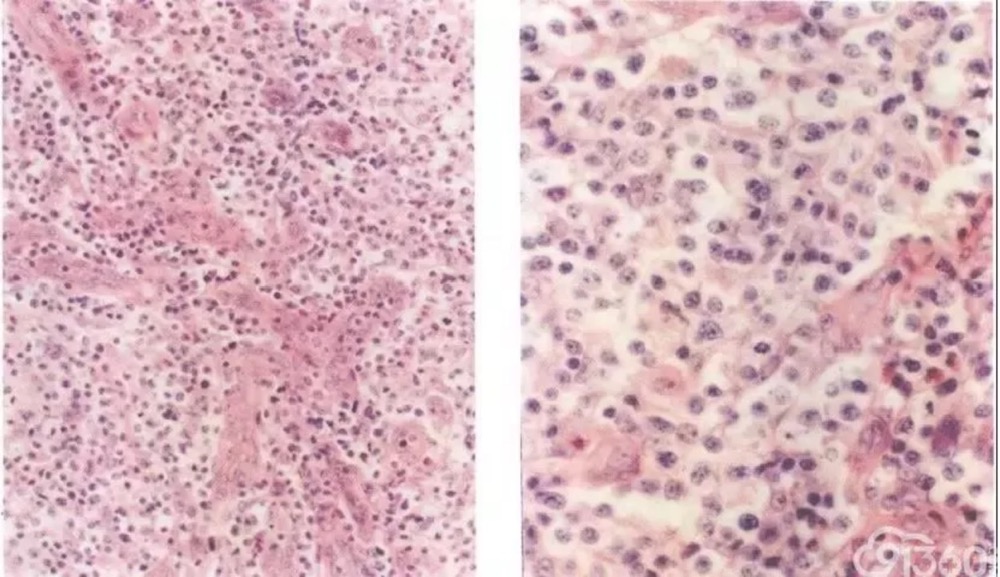
7923_h31v_6756.jpg

血管免疫母细胞性T细胞淋巴瘤是一种外周T细胞来源的肿瘤,临床上呈系统性疾病过程,全身多器官、组织受累,以瘤细胞的多形性,高内皮静脉和树突状网状细胞的明显增生为组织病理学。现已证实其为滤泡辅助T细胞来源的肿瘤。
临床表现
AITL占所有NHL的1%-2%,占所有外周T细胞肿瘤的15%-20%。患者多为老年人,平均年龄64岁。主要临床表现有发热、全身淋巴结大、肝脾大、贫血、皮肤瘙痒和多浆膜腔积液等。实验室检查可有多克隆高γ球蛋白血症、血清LDH水平升高、自身免疫性溶血性贫血、循环免疫复合物和自身抗体的存在等。约90%的患者就诊时已处于临床III期或IV期。不同的患者,该肿瘤的临床过程、预后及对治疗的反应差异较大,50%的患者用泼尼松治疗可达完全缓解,约30%的患者可获长无病生存期,但平均生存期少于3年。
病理改变
病变的早期淋巴滤泡常增生,随着肿瘤的进展,淋巴结结构不同程度地被破坏,但常见被膜下窦。滤泡间区增生,高内皮血管呈树枝状增生,遍布于病变的淋巴结。淋巴滤泡套区细胞消失,仅见少量滤泡中心细胞和增生的树突状网状细胞,即所谓生发中心“燃烧”现象。可见不等量的嗜酸性无结构物质沉着。多数瘤细胞体积小或中等大小,胞质淡染或透明,细胞核为圆形、卵圆形或不规则形,核染色质细腻而均匀分布。瘤细胞多呈小簇状分布,在低、中倍镜下呈特征性的斑驳样图像。常可见一些胞质嗜碱性的免疫母细胞呈簇状分布或存在于血管内。可见R-S样细胞(免疫表型检测呈CD30+,CD15+,CD20+/-,EBER+)。易见核分裂象。随着肿瘤的进展,瘤细胞的数量逐渐增加,成片分布。该肿瘤的形态学特征之一是滤泡外高内皮血管周围树突状细胞增生而形成粉染的细胞稀疏区。背景中还可见不等量的浆细胞、嗜酸性粒细胞和组织细胞散在分布,部分病例可见上皮样细胞簇或肉芽肿。
免疫表型与遗传学
瘤细胞表达T细胞分化抗原,如CD2,CD3和CD5。多数病例之瘤细胞为CD4表型。其肿瘤细胞特征地表达滤泡辅助T细胞标记,如CXCL13,CD10和PD-1。CD21染色显示滤泡外树突状网状细胞主要沿高内皮血管呈丛状增生,并勾勒出生发中心的轮廓。
病变组织中散在分布的B免疫母细胞表达CD20抗原,且常为EREB阳性。KI-67指数较高。约90%的病例可检出T细胞受体基因的克隆性重排,最常见的细胞遗传学异常是3号染色体三体、5号染色体三体和外加一X染色体。散在细胞存在EB病毒序列。
鉴别诊断
该肿瘤的临床和病理形态学表现均有一定的特点,加之其瘤细胞的免疫表型特征,如表达滤泡辅助T细胞抗原(CXCL13,PD-1和CD10),存在特征性的滤泡外树突状网状细胞网(CD21+)等,对绝大多数肿瘤可获诊断。需要提出与该肿瘤鉴别的疾病有:
1.富于T细胞和(或)组织细胞的大B细胞淋巴瘤
2.经典型霍奇金淋巴瘤
3.非特指外周T细胞淋巴瘤
免疫表型和抗原受体基因重排检测有助于上述肿瘤的鉴别诊断,而非特指外周T细胞淋巴瘤的诊断时在排除了其他组织学类型的T细胞淋巴瘤的基础上进行的。
参考文献:
[1]来茂德.病理学高级教程[M],123.
[2]朱梅刚,林汉良.淋巴瘤病理诊断图谱[M],14-142.